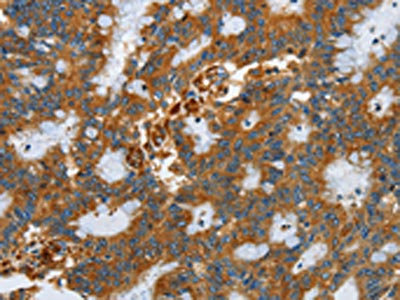

SEPT9 Antibody
-
中文名稱:SEPT9兔多克隆抗體
-
貨號:CSB-PA286864
-
規格:¥1100
-
圖片:
-
The image on the left is immunohistochemistry of paraffin-embedded Human cervical cancer tissue using CSB-PA286864(SEPT9 Antibody) at dilution 1/25, on the right is treated with fusion protein. (Original magnification: ×200)
-
The image on the left is immunohistochemistry of paraffin-embedded Human colon cancer tissue using CSB-PA286864(SEPT9 Antibody) at dilution 1/25, on the right is treated with fusion protein. (Original magnification: ×200)
-
-
其他:
產品詳情
-
Uniprot No.:
-
基因名:SEPT9
-
別名:AF17q25 antibody; Cell division control protein septin D1 antibody; KIAA0991 antibody; MLL septin like fusion protein antibody; MLL septin-like fusion protein antibody; MLL septin-like fusion protein MSF-A antibody; MSF antibody; MSF1 antibody; NAPB antibody; Ov/Br septin antibody; Ovarian/breast septin alpha antibody; Ovarian/Breast septin antibody; PNUTL4 antibody; SEPT9 antibody; SEPT9_HUMAN antibody; SeptD1 antibody; Septin 9 antibody; Septin D1 antibody; Septin-9 antibody; SINT1 antibody
-
宿主:Rabbit
-
反應種屬:Human,Mouse,Rat
-
免疫原:Fusion protein of Human SEPT9
-
免疫原種屬:Homo sapiens (Human)
-
標記方式:Non-conjugated
-
抗體亞型:IgG
-
純化方式:Antigen affinity purification
-
濃度:It differs from different batches. Please contact us to confirm it.
-
保存緩沖液:-20°C, pH7.4 PBS, 0.05% NaN3, 40% Glycerol
-
產品提供形式:Liquid
-
應用范圍:ELISA,IHC
-
推薦稀釋比:
Application Recommended Dilution ELISA 1:2000-1:5000 IHC 1:25-1:100 -
Protocols:
-
儲存條件:Upon receipt, store at -20°C or -80°C. Avoid repeated freeze.
-
貨期:Basically, we can dispatch the products out in 1-3 working days after receiving your orders. Delivery time maybe differs from different purchasing way or location, please kindly consult your local distributors for specific delivery time.
-
用途:For Research Use Only. Not for use in diagnostic or therapeutic procedures.
相關產品
靶點詳情
-
功能:Filament-forming cytoskeletal GTPase. May play a role in cytokinesis (Potential). May play a role in the internalization of 2 intracellular microbial pathogens, Listeria monocytogenes and Shigella flexneri.
-
基因功能參考文獻:
- Thus our data indicate that Sept9_i2 is a negative regulator of breast tumorigenesis. We propose that Sept9 tumorigenic properties depend on the balance between Sept9_i1 and Sept9_i2 expression levels. PMID: 28338090
- The plasma levels of septin-9 and clusterin in ovarian cancer patients were abnormally elevated, which might be used as potential candidates of peripheral blood tumor biomarkers for early diagnosis of EOC and septin-9 might be related to distal metastases of EOC. PMID: 29970704
- The primary aim of this study was to evaluate the diagnostic accuracy of a PCR-based assay for the analysis of SEPT9 promoter methylation in circulating cell-free DNA (mSEPT9) for diagnosing hepatocellular carcinoma. PMID: 29627389
- Septin 9 regulates lipid droplet growth through binding to phosphatidylinositol-5-phosphate in Hepatitis C virus infected cells.Septin 9 regulates lipid droplets growth and perinuclear accumulation in a manner dependent on dynamic microtubules.Septin 9 regulates Hepatitis C virus replication. PMID: 27417143
- The SEPT9 assay exhibited satisfactory performance in colorectal cancer diagnosis and screening, while more evidence is needed for therapeutic effect monitoring and prognosis prediction. PMID: 28128742
- Studies indicate that methylated Septin 9 ((m)SEPT9) can be consistently detected in plasma samples derived from whole blood samples collected with S-Monovette(R) K3E and BD Vacutainer (R) K2EDTA tubes stored at 2-8 degrees C for a maximum of 24 h and for samples collected in S-Monovette CPDA tubes stored at 18-25 degrees C for up to 48 h. PMID: 27753040
- our study has validated a new SEPT9 assay and combined testing as an aid in cancer detection, providing a new approach for opportunistic CRC screening. PMID: 27133379
- Study shows a stepwise increase of SEPT9 methylation from non-cancerous to cancerous tissue in colorectal adenocarcinoma. PMID: 27660666
- Study found SHOX2 and SEPT9 frequently methylated in biliary tract cancers. PMID: 27999621
- These results indicate that SEPT9_v2 promoter hypermethylation, which silences the expression of SEPT9_v2 mRNA, is observed in a significant proportion of breast tumors, and that methylated SEPT9_v2 may serve as a novel tumor marker for breast cancer. PMID: 27499429
- The first evidence of an interaction between septins and a nonmitotic kinesin is provided and it is suggested that SEPT9 modulates the interactions of KIF17 with membrane cargo. PMID: 26823018
- SEPT9 promoter methylation and MN frequency, both measured in peripheral blood, occur at an early stage compared to carcinoma development, indicating that the approach might be suitable to monitor CRC development. PMID: 26633373
- KRAS mutations and SEPT9 promoter methylation were present in 34% (29/85) and in 82% (70/85) of primary tumor tissue samples. PMID: 25946211
- SEPT9_i1 is expressed in high-grade prostate tumors suggesting it has a significant role in prostate tumorigenesis. PMID: 25898316
- we demonstrate that SEPT9 negatively regulates EGFR degradation by preventing the association of the ubiquitin ligase Cbl with CIN85, resulting in reduced EGFR ubiquitylation PMID: 25472714
- provide a full overview of the theoretical basis, development, validation, and clinical applications of the SEPT9 assay for both basic science researchers and clinical practitioners PMID: 26471083
- Results show that in plasma samples, elevated methylated SEPT9 (mSEPT9) values were detected in colorectal cancer, but not in adenomas. Tissue levels of mSEPT9 alone are not sufficient to predict mSEPT9 levels in plasma. PMID: 25526039
- Authors report here that the septins SEPT2, -9, -11, and probably -7 form fibrillar structures around the chlamydial inclusion. PMID: 25293760
- Our results suggest that SEPT9 gene methylation is a valuable biomarker for screening CRC in the Chinese population PMID: 24535900
- SEPT9 promoter methylation is detected in free circulating DNA of lung cancer patients PMID: 24633736
- The study shows increased SEPT9 expression as a consequence of genomic amplification and is the first study to profile SEPT9_v1 through SEPT9_v7 isoform-specific mRNA expression in tumor and nontumor tissues from patients with breast cancer. PMID: 24127542
- prognostic value of SHOX2 and SEPT9 DNA methylation in benign, paramalignant and malignant pleural effusions PMID: 24386354
- epigenetic deregulation of SEPT9 plays a role in the development of colorectal cancer. Aberrant hypermethylation of this gene occurs only in one of its CpG islands and this hypermethylation likely is an early event in the adenoma-carcinoma sequence. PMID: 23988185
- SEPT9 repeat motifs bind and bundle MTs, and thereby promote asymmetric neurite growth. PMID: 24344182
- SEPT9 isoform 1 is required for the association between HIF-1alpha and importin-alpha to promote efficient nuclear translocation. PMID: 24067372
- SEPT2 forms a 1:1:1 complex with SEPT7 and SEPT9. PMID: 23572511
- Serum methylation levels of TAC1, SEPT9, and EYA4 were significant discriminants between stage I colorectal cancer and healthy controls. PMID: 23862763
- SEPT9 plays multiple roles in abscission, one of which is regulated by the action of Cdk1 and Pin1. PMID: 23990466
- The identification of a SEPT9 mutation in a neonate with respiratory distress due to vocal cord paralysis expands the differential diagnosis in these patients. PMID: 22981636
- Matrix stiffness regulates endothelial cell proliferation through septin 9 PMID: 23118862
- SEPT9 in plasma has a role in both left- and right-sided colon cancers PMID: 23049919
- Myeloid K562 cells express three SEPT9 isoforms, all of which have an equal propensity to hetero-oligomerize with SEPT7-containing hexamers to generate octameric heteromers. PMID: 22956766
- SEPT9_v4 expression may be clinically relevant and contribute to some forms of drug resistance. PMID: 22278362
- SEPT9 gene amplification and overexpression during human breast tumorigenesis PMID: 21831286
- Data illustrated roles of SEPT9 that might contribute to hetero-trimeric septin complex formation. SEPT9 can substitute for septins of the SEPT2 group and partially for SEPT7. PMID: 21767235
- SEPT9 holds a terminal position in the septin octamers, mediating abscission-specific polymerization during cytokinesis. PMID: 22123865
- uneven distribution of SEPT9 among core septin heteromers causes heterogeneity with respect to both subunit number and polymerization interfaces PMID: 21737677
- Increased methylation of septin 9 resulting in decreased mRNA and protein expression is associated with colorectal cancer. PMID: 21267688
- Data demonstrate that SEPT9 mediates the localization of the vesicle-tethering exocyst complex to the midbody, providing mechanistic insight into the role of SEPT9 during cell division. PMID: 21059847
- A total of seven heterogeneous SEPT9 duplications have been identified in this study as a causative factor of hereditary neuralgic amyotrophy. PMID: 19939853
- New insights and validation are provided for applying SEPT9 transcript variant 1 as a potential target for antitumor therapy via interruption of the HIF-1 pathway. PMID: 20407014
- Data show that methylated DNA from advanced precancerous colorectal lesions can be detected using a panel of two DNA methylation markers, ALX4 and SEPT9. PMID: 20140221
- Case represents an additional MLL-SEPT9-positive AML that was considered to be related to therapy. RT-PCR and sequencing analyses demonstrated MLL-SEPT9 fusion transcripts with the breakpoint of MLL exon 8/SEPT9 exon 2 and MLL exon 9/SEPT9 exon 2. PMID: 20682395
- Results verify IRX1, EBF3, SLC5A8, SEPT9, and FUSSEL18 as valid methylation markers in two separate sets of HNSCC specimens; also preliminarily show a trend between HPV16 positivity and target gene hypermethylation of IRX1, EBF3, SLC5A8, and SEPT9. PMID: 20029986
- Coexistence of alternative MLL-SEPT9 fusion transcripts in an acute myeloid leukemia with t(11;17)(q23;q25). PMID: 20113838
- Fusion of MLL and MSF in adult de novo acute myelomonocytic leukemia (M4) with t(11;17)(q23;q25). PMID: 12095151
- These results reveal that MSF is required for the completion of cytokinesis and suggest a role that is distinct from that of Nedd5. PMID: 12388755
- Filament formation of MSF-A, a mammalian septin, in human mammary epithelial cells depends on interactions with microtubules PMID: 12626509
- Sept7/9b/11 form a complex that has effects on filament elongation, bundling, or disruption PMID: 15485874
- overexpression of SEPT9 in neoplasia is not simply a proliferation-associated phenomenon, despite its role in cytokines PMID: 15782116
顯示更多
收起更多
-
相關疾病:Hereditary neuralgic amyotrophy (HNA)
-
亞細胞定位:Cytoplasm, cytoskeleton. Note=In an epithelial cell line, concentrates at cell-cell contact areas. After TGF-beta1 treatment and induction of epithelial to mesenchymal transition, colocalizes partly with actin stress fibers. During bacterial infection, displays a collar shape structure next to actin at the pole of invading bacteria.
-
蛋白家族:TRAFAC class TrmE-Era-EngA-EngB-Septin-like GTPase superfamily, Septin GTPase family
-
組織特異性:Widely expressed. Isoforms are differentially expressed in testes, kidney, liver heart, spleen, brain, peripheral blood leukocytes, skeletal muscle and kidney. Specific isoforms appear to demonstrate tissue specificity. Isoform 5 is the most highly expres
-
數據庫鏈接:
Most popular with customers
-
-
YWHAB Recombinant Monoclonal Antibody
Applications: ELISA, WB, IHC, IF, FC
Species Reactivity: Human, Mouse, Rat
-
Phospho-YAP1 (S127) Recombinant Monoclonal Antibody
Applications: ELISA, WB, IHC
Species Reactivity: Human
-
-
-
-
-